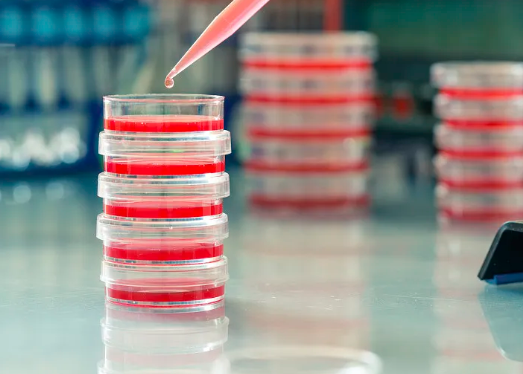
image.png

臍帶血干細(xì)胞存儲(chǔ)量,臍帶血干細(xì)胞存儲(chǔ)多少錢一年
2024-08-01 15:04:50 來源: 小編 咨詢醫(yī)生
隨著醫(yī)學(xué)技術(shù)的發(fā)展,臍帶血干細(xì)胞存儲(chǔ)逐漸受到關(guān)注。臍帶血干細(xì)胞具有多種醫(yī)學(xué)應(yīng)用價(jià)值,其存儲(chǔ)量和費(fèi)用是許多人關(guān)心的問題。本文將詳細(xì)探討臍帶血干細(xì)胞的存儲(chǔ)量及存儲(chǔ)費(fèi)用。
臍帶血干細(xì)胞的醫(yī)學(xué)應(yīng)用
臍帶血干細(xì)胞是從新生兒臍帶血中提取的造血干細(xì)胞,具有多向分化和再生能力,廣泛應(yīng)用于治療多種疾病,如白血病、再生障礙性貧血、免疫缺陷病等。近年來,臍帶血干細(xì)胞還被研究用于治療腦癱、自閉癥等神經(jīng)系統(tǒng)疾病,顯示出廣闊的應(yīng)用前景。
臍帶血干細(xì)胞的存儲(chǔ)量
臍帶血干細(xì)胞的存儲(chǔ)量受多種因素影響,包括臍帶血的采集量、提取技術(shù)、存儲(chǔ)條件等。一般來說,每份臍帶血中含有的干細(xì)胞數(shù)量足以用于治療一個(gè)成年人的標(biāo)準(zhǔn)體重(70公斤)的多次治療。
- 采集量:臍帶血的采集量直接影響干細(xì)胞的存儲(chǔ)量。一般情況下,每份臍帶血的采集量約為80-120毫升。
- 提取技術(shù):先進(jìn)的提取技術(shù)能夠提高干細(xì)胞的提取率,增加存儲(chǔ)量。
-
存儲(chǔ)條件:嚴(yán)格的低溫存儲(chǔ)條件能夠保證干細(xì)胞的活性和存儲(chǔ)量。
臍帶血干細(xì)胞存儲(chǔ)多少錢一年
臍帶血干細(xì)胞的存儲(chǔ)費(fèi)用因地區(qū)、存儲(chǔ)機(jī)構(gòu)、存儲(chǔ)年限等因素而異。一般來說,臍帶血干細(xì)胞的存儲(chǔ)費(fèi)用包括一次性的采集和處理費(fèi)用,以及每年的存儲(chǔ)費(fèi)用。
- 采集和處理費(fèi)用:一次性的采集和處理費(fèi)用一般在5,000元至10,000元不等。
- 存儲(chǔ)費(fèi)用:每年的存儲(chǔ)費(fèi)用一般在1,000元至2,000元不等。
以一家國(guó)內(nèi)知名的臍帶血干細(xì)胞存儲(chǔ)機(jī)構(gòu)為例,其具體費(fèi)用如下:
- 一次性采集和處理費(fèi)用:8,000元。
- 每年的存儲(chǔ)費(fèi)用:1,200元。
根據(jù)存儲(chǔ)年限的不同,總費(fèi)用也有所不同。例如,存儲(chǔ)20年的總費(fèi)用約為32,000元。
臍帶血干細(xì)胞存儲(chǔ)的優(yōu)勢(shì)
- 醫(yī)療保障:臍帶血干細(xì)胞能夠用于治療多種重大疾病,是一種重要的醫(yī)療保障。
- 自體使用:自體臍帶血干細(xì)胞不會(huì)引起免疫排斥反應(yīng),安全性高。
- 多向分化:臍帶血干細(xì)胞具有多向分化能力,應(yīng)用范圍廣。
存儲(chǔ)臍帶血干細(xì)胞的注意事項(xiàng)
- 選擇正規(guī)機(jī)構(gòu):選擇有資質(zhì)的正規(guī)存儲(chǔ)機(jī)構(gòu),確保存儲(chǔ)的安全性和可靠性。
- 詳細(xì)了解費(fèi)用:在簽訂存儲(chǔ)合同時(shí),詳細(xì)了解費(fèi)用構(gòu)成,避免后期出現(xiàn)不必要的糾紛。
- 定期檢查:定期檢查存儲(chǔ)狀況,確保干細(xì)胞的活性和安全性。
未來發(fā)展前景
隨著技術(shù)的不斷進(jìn)步,臍帶血干細(xì)胞的應(yīng)用范圍將不斷擴(kuò)大。未來,臍帶血干細(xì)胞有望在更多疾病的治療中發(fā)揮重要作用,為人類健康帶來更多保障。
總之,臍帶血干細(xì)胞的存儲(chǔ)是一項(xiàng)具有重要醫(yī)學(xué)價(jià)值的選擇,雖然存儲(chǔ)費(fèi)用較高,但其帶來的醫(yī)療保障和應(yīng)用前景不容忽視。在選擇存儲(chǔ)機(jī)構(gòu)時(shí),需綜合考慮費(fèi)用、存儲(chǔ)條件和機(jī)構(gòu)資質(zhì),確保干細(xì)胞的安全存儲(chǔ)和有效應(yīng)用。
- 2024-08-23臍帶干細(xì)胞存儲(chǔ)收費(fèi)多少錢一年
- 2024-09-22深圳儲(chǔ)存干細(xì)胞費(fèi)用,一文全面解析
- 2024-09-11臍帶造血干細(xì)胞存儲(chǔ)條件和方法
- 2024-11-12山東醫(yī)美干細(xì)胞存儲(chǔ)有哪些,靠譜嗎
- 2024-09-26廣州干細(xì)胞儲(chǔ)存費(fèi)用,附上機(jī)構(gòu)價(jià)格明細(xì)
- 2024-10-25合肥人體干細(xì)胞存儲(chǔ)哪家可靠?存儲(chǔ)費(fèi)用如何?
- 2024-08-04乳牙干細(xì)胞保存費(fèi)用,乳牙干細(xì)胞怎么保存
- 2024-10-11儲(chǔ)存新生兒臍帶干細(xì)胞需要多少錢??jī)r(jià)格因素有哪些?
- 2024-10-05干細(xì)胞醫(yī)院用處大嗎?哪家醫(yī)院干細(xì)胞移植更靠譜?
- 2024-10-10干細(xì)胞存儲(chǔ)設(shè)備企業(yè)哪家靠譜?如何選擇儲(chǔ)存服務(wù)?
- 2024-09-09干細(xì)胞對(duì)面部的功效,干細(xì)胞填充面部好不好
- 2024-09-15上海干細(xì)胞再生牙機(jī)構(gòu),收好這機(jī)構(gòu)名單
- 2024-09-28干細(xì)胞真能改善失眠嗎,其功效如何驗(yàn)證
- 2024-09-11哪里可以注射干細(xì)胞,干細(xì)胞注射機(jī)構(gòu)排名
- 2024-08-10干細(xì)胞治療的原理和方法
- 2024-09-05干細(xì)胞填充全過程及注意事項(xiàng)
- 2024-09-03多能干細(xì)胞研究進(jìn)展,多能干細(xì)胞的作用和功效
- 2024-09-12蘋果干細(xì)胞有副作用嗎,附功效和注意事項(xiàng)
